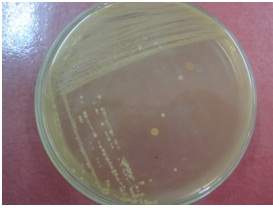
MEDIA PERTUMBUHAN MIKROBA | YANJUZ
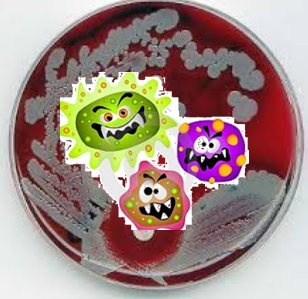
Bentuk, Susunan dan Sifat Media untuk Pertumbuhan Bakteri - Ruang

Media Pertumbuhan Bakteri
Media Pertumbuhan Mikroba
Jenis Jenis Media Pertumbuhan Bakteri

Bentuk, Susunan dan Sifat Media untuk Pertumbuhan Bakteri
Media pertumbuhan bakteri merupakan suatu zat atau bahan yang digunakan untuk memberikan dukungan nutrisi bagi bakteri dan juga menyediakan kondisi yang optimal untuk pertumbuhan serta perkembangbiakan mereka. Media ini dapat berupa cairan, padat, atau setengah padat, tergantung pada jenis bakteri yang ingin dikulturkan. Banyak sekali jenis dan varian media pertumbuhan yang digunakan dalam bidang mikrobiologi untuk tujuan penelitian, diagnostik, atau produksi.
Apa itu Media Pertumbuhan Bakteri?
Media pertumbuhan bakteri adalah suatu bahan yang digunakan sebagai nutrisi bagi bakteri dalam proses perkembangbiakannya. Media ini memberikan semua zat-zat yang dibutuhkan oleh bakteri, seperti karbohidrat, protein, mineral, dan vitamin, sehingga memungkinkan mereka untuk tumbuh dan berkembang secara normal. Media pertumbuhan juga menyediakan kondisi fisik seperti pH, suhu, dan kelembaban yang optimal bagi pertumbuhan bakteri.
Ciri-Ciri Media Pertumbuhan Bakteri
Media pertumbuhan bakteri memiliki beberapa ciri-ciri penting yang harus dipenuhi agar dapat mendukung pertumbuhan dan perkembangbiakan bakteri dengan baik. Berikut adalah beberapa ciri-ciri media yang umum digunakan dalam kultur bakteri:
- Memiliki komposisi nutrisi yang sesuai dengan kebutuhan bakteri
- Mudah disiapkan dan dapat dijumpai dengan mudah
- Tidak mengandung zat yang bersifat menghambat pertumbuhan bakteri
- Bersifat steril, tidak terkontaminasi oleh mikroorganisme lain
- Mampu mendukung perkembangbiakan bakteri dengan cepat dan efisien
- Dapat membedakan jenis-jenis bakteri berdasarkan kriteria tertentu
Klasifikasi Media Pertumbuhan Bakteri
Media pertumbuhan bakteri dapat diklasifikasikan berdasarkan beberapa kriteria, seperti formulasi kimia, sifat fisik, atau tujuan penggunaannya. Berikut adalah beberapa klasifikasi umum media pertumbuhan bakteri:
- Media Dasar: Media yang digunakan sebagai dasar dalam pembuatan media khusus dengan menambahkan suplemen tertentu.
- Media Seletif: Media yang mengandung bahan tertentu yang mampu menghambat pertumbuhan beberapa jenis bakteri dan memungkinkan tumbuhnya jenis bakteri tertentu saja.
- Media Diferensial: Media yang mengandung zat-zat yang dapat membedakan dan mengidentifikasi jenis-jenis bakteri berdasarkan perubahan warna atau karakteristik pengelompokan.
Jenis-Jenis Media Pertumbuhan Bakteri
Ada berbagai jenis media pertumbuhan yang digunakan dalam kultur bakteri, tergantung pada tujuan penggunaannya. Berikut adalah beberapa jenis media pertumbuhan bakteri yang umum digunakan:
- Media Agar Padat: Media yang mengandung agar sebagai pengental agar membentuk gel saat diinkubasi. Media ini digunakan untuk mengisolasi dan menghitung jumlah koloni bakteri.
- Media Cair: Media yang berupa larutan nutrisi yang tidak mengandung agar atau pengental lainnya. Media ini digunakan untuk pertumbuhan bakteri dalam jumlah besar.
- Media Setengah Padat: Media yang mengandung agar dalam jumlah yang lebih sedikit daripada media agar padat. Media ini digunakan untuk mengamati perilaku dan morfologi bakteri.
- Media Darah: Media yang mengandung darah sebagai sumber nutrisi tambahan. Media ini digunakan untuk mengkarakterisasi bakteri patogen.
Cara Berkembang Biak Bakteri
Pertumbuhan dan perkembangbiakan bakteri dapat terjadi melalui dua cara, yaitu:
- Pembelahan Biner: Bakteri dapat berkembang biak dengan cara membelah diri menjadi dua individu yang identik. Proses ini terjadi dengan cepat dan memungkinkan pertumbuhan koloni bakteri dalam jumlah besar dalam waktu yang relatif singkat.
- Transduksi: Bakteri juga dapat berkembang biak melalui proses transduksi, yaitu transfer genetik dari satu bakteri ke bakteri lain menggunakan virus bakteriofag sebagai perantara. Proses ini berperan dalam transfer sifat-sifat genetik seperti resistensi antibiotik atau kemampuan patogenik.
Contoh Media Pertumbuhan Bakteri
Berikut adalah beberapa contoh media pertumbuhan bakteri yang sering digunakan dalam kultur mikroba:
- Media Nutrient Agar (NA): Media dasar yang digunakan sebagai media umum untuk pertumbuhan bakteri. Media ini mengandung semua zat-zat nutrisi penting yang dibutuhkan oleh bakteri.
- Media MacConkey Agar (MCA): Media selektif dan diferensial yang digunakan untuk mengisolasi dan mengidentifikasi bakteri Gram negatif, terutama bakteri enterik seperti E. coli.
- Media Eosin Methylene Blue (EMB): Media selektif dan diferensial yang digunakan untuk mengisolasi dan mengidentifikasi bakteri Gram negatif, terutama bakteri enterik seperti E. coli.
Kesimpulan
Media pertumbuhan bakteri merupakan bahan yang digunakan untuk memberikan dukungan nutrisi bagi bakteri serta menyediakan kondisi yang optimal untuk pertumbuhan dan perkembangbiakan mereka. Media ini sangat penting dalam dunia mikrobiologi untuk tujuan penelitian, diagnostik, maupun produksi. Terdapat berbagai macam jenis media pertumbuhan bakteri, seperti agar padat, cair, dan setengah padat, serta berbagai jenis media selektif dan diferensial. Dalam proses pertumbuhan bakteri, mereka dapat berkembang biak melalui pembelahan biner dan proses transduksi. Contoh-contoh media pertumbuhan yang sering digunakan antara lain Nutrient Agar, MacConkey Agar, dan Eosin Methylene Blue.



